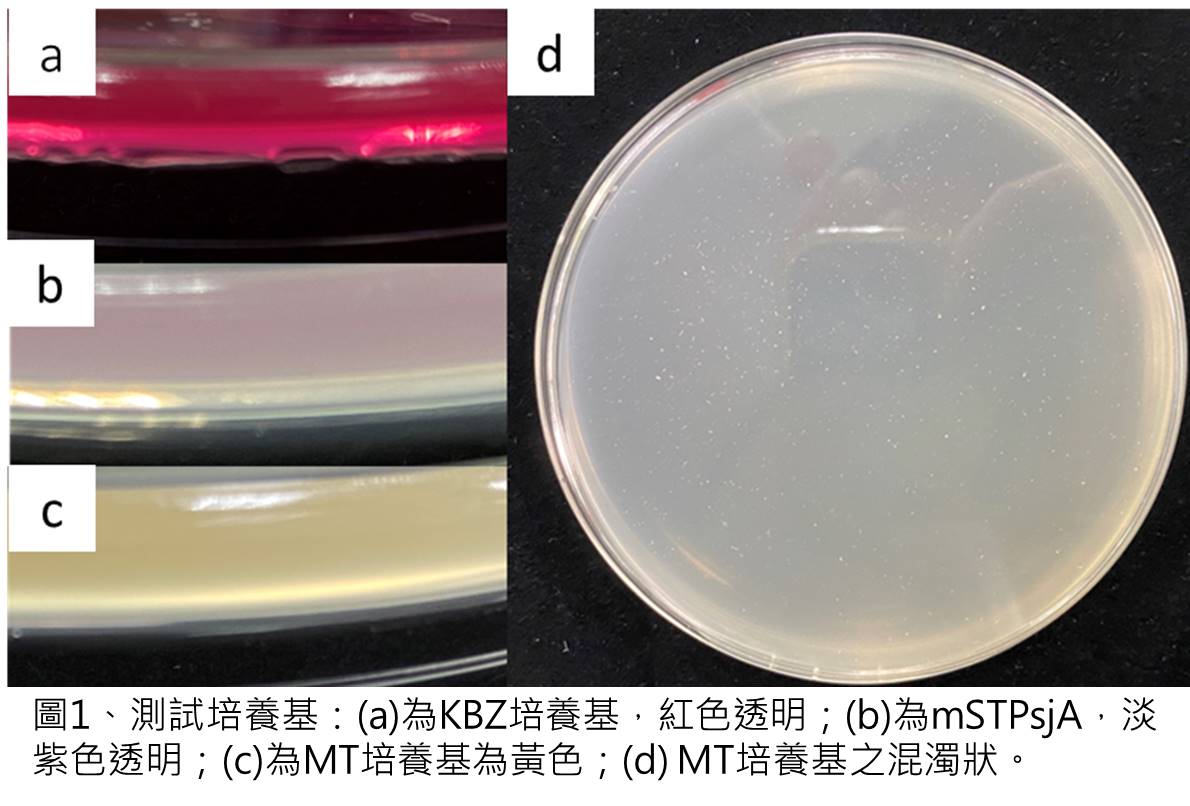
Fig.1.

Home > Achievement > 2020 Research Project List > Research on optimization of detecting operation procedure for seed-borne pathogens |
The goal of this program in 2020 was to improve the operating procedure for detecting Pseudomonas spp. in order to decrease costs on money and manpower. The results of testing semi-selective media showed that Pseudomonas syringae pv. tomato (Pst)、P. viridiflava (Pv) and P. cichorii (Pc) could be incubated on mSTPsjA medium and KBZ medium with similar colony morphology. On MT medium, however, clear zones showed only around Pst colonies but not Pv and Pc colonies. Therefore, MT medium and KBZ medium could be used with each other so that the identification would get better. The amplification for Pst, Pv and Pc was modified to the same conditions to improve the PCR efficiency.
▲Fig.1.

▲Fig.2.